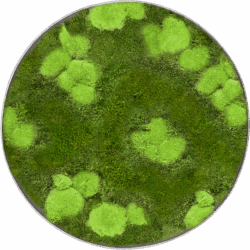
Moosbild Nova Frame Natural-concrete 30% Ball- und 70% Plattenmoos D 40 / Preis a.A

von regionalen Erzeugern bezogen
Pflanzen, die Dich glücklich machen
Begrünungs Konzepte
Wir von GooDeco folgen bei der Auswahl von Grünpflanzen und bei der Fertigstellung unserer Begrünungskonzepte der Maxime, Nachhaltigkeit und Frische und sind in der Lage verschiedene Systeme anzubieten.
Jahrzehntelange Erfahrung
Dank der Zusammenarbeit mit unseren ausgesuchten Partnern sind wir in der Lage Ihnen an großes und wechselndes Angebot und eine langjährige professionelle Erfahrung anbieten zu können.
Ihr GooDeco Team
Pflanzenverleih
Bei uns erhalten Sie ein großes und wechselndes Angebot an Pflanzen zum Verleih für Ihre Objekt oder Ihr Event. Florale Werkstücke werden bei uns ebenfalls individuell für Ihr Event angefertigt und die Lieferung erfolgt bis vor die Tür
NEU
Gefäßverleih
Gefäßverleih
Gefäßverleih
Gefäßverleih
Begrünungskonzepte

Büroetage

Dachterrasse

Eingangsbereich
Wir lieben was wir tun
Jedes Stück ist ein handgefertigtes Unikat und garantiert ein unverwechselbarer Blickfang zu jedem Anlass. Formschön, elegant und attraktiv – auch im Preis!
Gefäße
Gefäßverleih
Gefäßverleih
Gefäßverleih
Gefäßverleih
Begrünung
Eine kleine Auswahl unserer Leihpflanzen!
Eine weitere Auswahl unserer Pflanzen finden Sie auch im Shop.
Für den Verleih sprechen Sie uns bitte an
Ficus Benjamini
h 120 -200 cm / ab 21 €
Areca Palme
h 140 – 240 cm / ab 48 €
Olivenbaum
h 140 – 240 cm / ab 51 €
Efeuwand
b 80 cm / h 200 cm ab 75 €
Begrünungskonzepte
Wir von GooDeco folgen bei der Auswahl von Grünpflanzen und bei der Fertigstellung unserer Begrünungskonzepte der Maxime, Nachhaltigkeit und Frische und sind in der Lage verschiedene Systeme anzubieten.
Verleih
Gefäßverleih
Gefäßverleih
Gefäßverleih
Gefäßverleih
Pflanzenverleih
45,00 €
Pflanzenverleih
45,00 €
Pflanzenverleih
75,00 €
Pflanzenverleih
51,00 €
Verleih
48,00 €
Pflanzenverleih
21,00 €
NEU ! Unsere Moosbilder und Wände
Eine weitere Auswahl unserer Moosbilder finden Sie demnächst auch in unserem Shop & Service Bereich.
Für Sonderanfertigungen sprechen Sie uns gerne an
Moosbild
b 160 x h 40 cm /
Moosbild
h 100 – 200 cm /
Mooswand
h 220 – 350 cm /
Moosdekoration
-20%
Alter Preis: Ursprünglicher Preis war: 99,99 €79,99 €Aktueller Preis ist: 79,99 €.
-17%
Alter Preis: Ursprünglicher Preis war: 59,99 €49,99 €Aktueller Preis ist: 49,99 €.